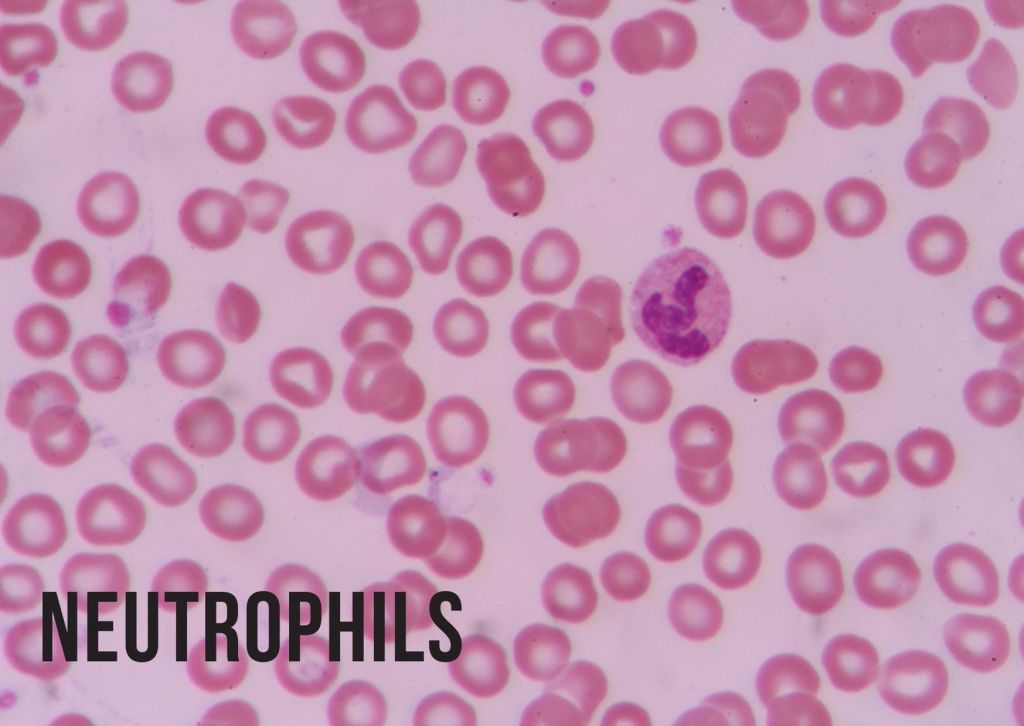

I was thinking about bacteria and I got the idea to make up a funny version of what happens when bacteria infects the body.
I hope you enjoy!
Part 1: The infection.
It was a normal day in the body, but on the outside, there were some very mean bacteria. These bacteria are known as Staphylococcus aureus. They were very mean. Human bodies are the perfect place to live for them. Plenty of nutrients going around the body makes life easier for the bacteria.
Staph aureus didn’t get past the first line of defence of the body, the skin. So they gave up. But then the skin got cut. The bacteria immediately swarmed to the inside of the body and started multiplying. Once they reached the surface, they started changing their behaviour and began attacking the body. But by that point, the ‘people’ guarding the body immediately noticed. All the red blood cells just ran away. Inside, the Staphylococcus Aureus thought they were doing pretty good until they reached near the stage one of the immune system inside the body, the neutrophils. You most likely know them as white blood cells. Neutrophils are the most common immune cells.

But the bacteria had pierced into the blood vessel and so they ended up meeting neutrophils. They almost got wiped out but then they doubled again and used coagulase to trap the neutrophils in fibrin. By that point the macrophages had noticed the bacteria and had gone in to help but they were slowly pushed back because they were much more powerful than a neutrophil. Then the dendritic cell got alerted and they were already on their way to the barracks. The barracks is another word for lymph node. Lymph nodes are where B cells and T cells are.

The dendritic cells got some samples of bacteria, then heads to the closest lymphnode and tries to find a T cell with the right setup. Then it finds one and starts multiplying. Some become memory T-cells, the majority become helper T cells and killer T cells. Killer T cells are basically the SWAT team of the immune system. The helper T cells then went to the B cell section to find a B cell with the right setup to activate. Once activated, B cells multiply and start making new things. Those new things are antibodies. And by that point a lot of the antibodes had been made. At the battle field, the immune system was being pushed back. But then the final line of defence arrived. Not really but in this version it is. Thousands of antibodies got attached to the bacteria and killed a lot of them. By that point the most of the guard cells had been at the point between life and death. But then the helper T-cells arrived and started to heal them (sort of).

Finally the bacteria got exterminated.

The wound healed eventually.That’s because of platelets. Platelets create fibrin to cover up wounds so bacteria can’t come in. Then they get cells into the wound to heal it.
Leave a comment